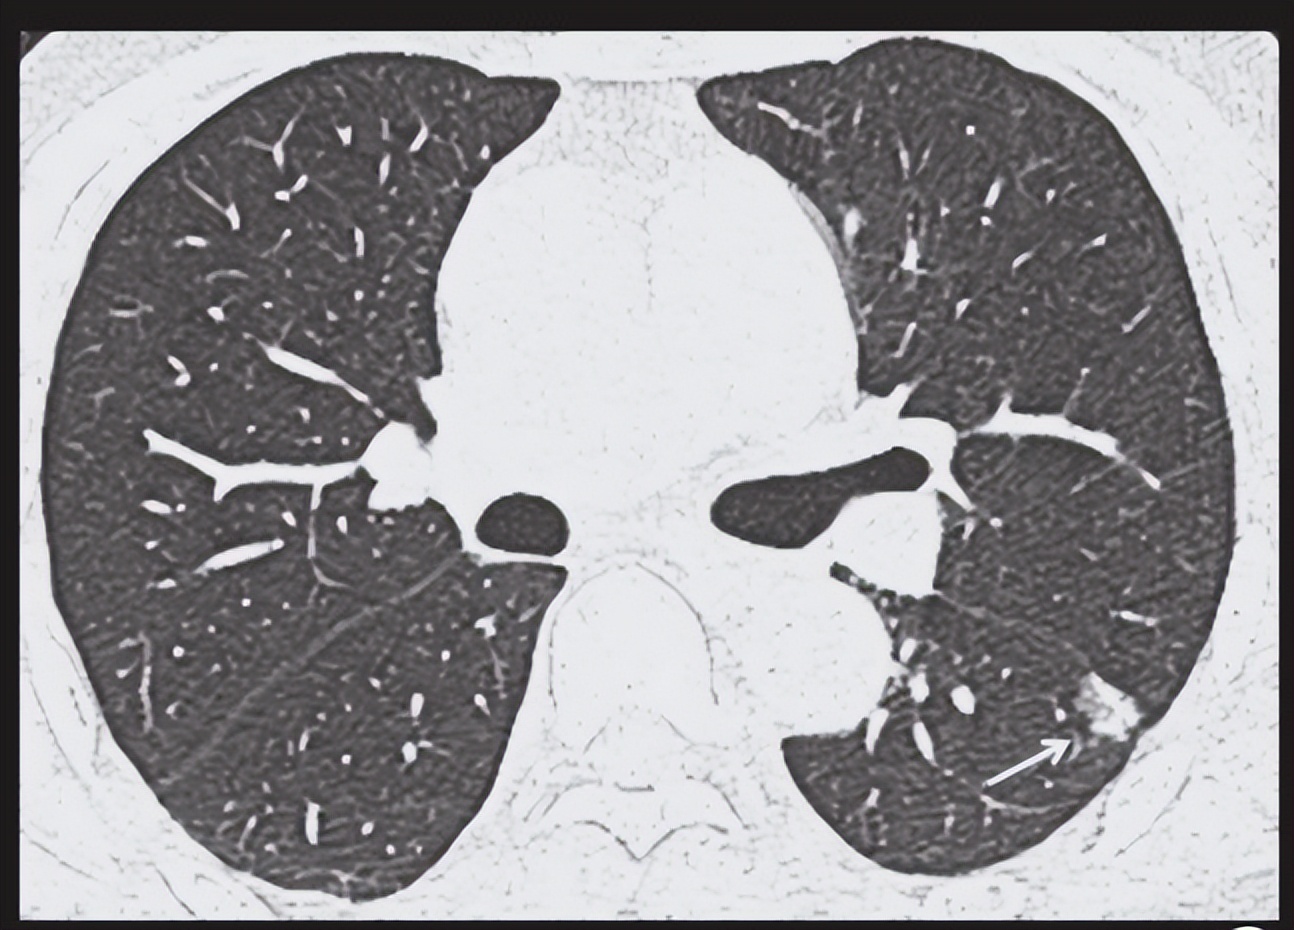
5mm的磨玻璃结节有胸痛症状好吗,胸痛拍ct会检查出病因

我一个叔叔爱抽烟,有一次他感觉胸痛、发烧、呼吸困难,去某肿瘤医院检查,CT上发现磨玻璃结节,结论上赫然写着:肺癌?
当时一看肺癌两字,就没有想想人家医生在后面还打折“?”问号,一家人都整蒙圈了,伤心了好一阵子。
出现胸痛症状,不要慌
引起胸痛的原因实在很多 ,心脏、肺部、纵膈、肌肉和骨骼、胸部神经、胃肠性疾病、血管疾病、其他疾病都可以引起胸痛, 并非胸痛都是由肺癌引起的。 简然罗列一下:
1、心脏:主动脉瓣病变、冠状动脉性疾病、心包炎、肺动脉高压、二尖瓣脱垂、特发性肥厚性者动脉下狭窄、心肌炎、心肌病等。
2、肺部:肺炎、肺栓塞、胸膜腔积液、气胸、肿瘤等。
3、纵膈:纵膈炎症、纵隔肿瘤、反流性食管炎、食管癌等。
4、肌肉和骨骼疾病:肌肉痉挛、肋软骨炎、肋间肌炎、胸腔出口综合征、肋骨和椎骨骨折等。
5、神经性:带状疱疹、神经纤维瘤等。
6、胃肠性:异物存留、食管炎、食管痉挛、食管破裂、消化性溃疡等。
7、血管病变:主动脉破裂。
8、其它:乳腺炎、乳腺肿瘤、过度通气、抑郁等。

胸痛部位和疼痛特点不同,预示的疾病不同,肺癌早期引起的胸痛反而不明显。
1、胸壁疾病:胸壁皮肤发生炎症,疼痛常常固定在病变部位,局部皮肤会出现发红、肿胀、发热等症状,深呼吸的时候疼痛会加重。
2、带状疱疹:疼痛沿着一侧肋间神经分布,一般是剧痛。
3、肋软骨炎:一般疼痛在第1、2软肋骨部位。
4、心肌梗死和心绞痛:疼痛多在心前区、胸骨后方和剑突下,可以向左侧内臂和左肩部位放射。也可以放射到面颊部位,常被误认为是牙痛。
5、主动脉夹层:疼痛多在胸背部,可以放射到腰部、下腹部和腹股沟、下肢部位。
6、食管和纵膈病变:疼痛多发生在胸骨后面,常常在吞咽的时候疼痛突然发生或加重。
7、肝胆疾病:疼痛多在右下胸部位。
8、肺癌:肺癌病人中20%-40%的人会出现胸痛症状。
- 隐痛:一般在肺癌早期,肿瘤细胞没有浸润、破坏周围组织,癌细胞释放一些致痛物质,只会引起胸部隐隐作痛。这个时候疼痛常常定位不准确。
- 放射痛:肿瘤组织逐渐增大,会压迫和损伤交感神经、臂丛神经,出现放射性疼痛,如肩膀、手臂等。
- 剧痛:肿瘤组织过大,直接侵犯、破坏肋骨、椎体、胸膜等组织,会出现剧烈疼痛。发生骨转移破坏骨质,导致病理性骨折时,会导致剧烈的骨性疼痛。
除了胸痛外,肺癌还会引起咳嗽、咯血、呼吸困难、声音嘶哑、胸腔积液等症状。
- 咳嗽:50%-75%的肺癌患者存在咳嗽症状,这是因为肺癌会导致气道分泌物增多,大量分泌物刺激呼吸道黏膜,而出现咳嗽。
- 咯血:咯血患者存在肺癌的可能性为3%-34%左右,咯血最常见的病因是支气管炎。
- 呼吸困难:大约25%-40%的患者会出现呼吸困难。肺癌导致气道管腔内外梗阻而引起呼吸困难,应注意的是阻塞性肺炎、肿瘤栓子、心包积液等疾病也会引起呼吸困难。
- 声音嘶哑:肺癌侵犯喉返神经时,会引起声音嘶哑。
- 胸腔积液:肺癌累及胸膜时会出现胸腔积液,一般为恶性胸腔积液。
恶性积液通常为渗出液,也可能为浆液、血清血液或肉眼可见的血性液体。在确定胸膜受累的患者中,单次胸腔穿刺后胸水细胞学检查的检出率约为60%;再次胸腔穿刺的检出率增至约75%,之后再行胸腔穿刺几乎不会再提高检出率。闭式胸膜活检几乎不会增加细胞学检查的检出率。对于疑似恶性肿瘤的患者,如果首次胸水细胞学检查为阴性则应复查,加或不加胸膜活检均可。

出现胸痛症状,怀疑是由肺癌引起,千万别慌,先要做个CT检查。
所有疑似肺癌者都应该接受胸部CT检查,最好行静脉造影增强,以便于区分原发瘤侵犯纵膈、血管结构和淋巴结转移。
CT检查中把直径≤2cm的病灶称为结节,大于2㎝的病灶称为肿块。
CT发现肺内密度增高影,但密度有不能掩盖病灶内支气管影和血管影的,称为磨玻璃影。如果病灶边界清楚,表现为结节状,呈圆形或类圆形,则为 磨玻璃结节 。
发现磨玻璃结节也别慌 ,应该说大部分-持续存在的磨玻璃结节是肺癌,但并不是说发现磨玻璃结节就等同于肺炎。碳末沉积、肺部炎症等一些良性病变也可能会出现磨玻璃结节。应进一步检查。
做CT检查可以定位病变组织。可以通过纤维支气管镜、经皮穿刺,做淋巴结或浅表肿物活检,体腔积液细胞学检查,或做胸腔镜、纵隔镜检查来帮助诊断。
病理学检查
●腺癌–肿瘤腺体形成或胞质内含有黏蛋白。
●鳞癌–肿瘤细胞产生角蛋白和/或可见细胞间桥粒(细胞间桥)。
●腺鳞癌–腺癌和鳞癌成分各占>10%。
●大细胞癌–未见腺样和鳞样分化特征(即,低分化NSCLC)
免疫组化染色如下:
●腺癌通常为甲状腺转录因子-1(thyroid transcription factor-1, TTF-1)、黏蛋白、napsin-A、surf-A、surf-B、PAS-D和CK7染色阳性。
●鳞癌通常为p40、p63和细胞角蛋白5/6(cytokeratin 5/6, CK5/6)染色阳性,CK7染色阴性。
●腺鳞癌或大细胞癌的免疫组化染色可能兼有腺癌和鳞癌的特征。
●低分化癌和从远处转移来的病灶需要与原发性NSCLC相鉴别。例如,在NSCLC中通常为染色阴性的是CK20(通常在结肠腺癌中为阳性)、雌激素受体和孕激素受体(通常在乳房腺癌中为阳性),从而能够鉴别肺部所见腺癌的组织起源。用于确定低分化癌组织起源的其他常见染色模式。鉴别NSCLC与SCLC的染色(如,嗜铬粒蛋白)将单独介绍。

如果胸部影像学、病理学诊断确诊为肺癌,应积极配合医生治疗。